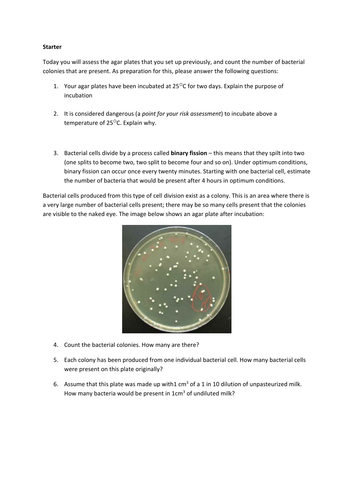

Prokaryotes Bacteria Worksheet Answers

Prokaryotes bacteria worksheet answers.
Prokaryotes bacteria worksheet answers.Bacteria are prokaryotes that fall into two major categories.Bacteria shapes worksheets learny kids some of the worksheets for this concept are shapes of bacteria work answers name period date unit online bacteria for breakfast cell virus structures morphology and notes classification of bacteria prokaryotic and eukaryotic cells bacteria and viruses identifying bacteria general work infectious non infectious diseases session 8 viruses and bacteria key concepts.Dna is protected by nucleus in plant and animal cells 3.
There are also examples of specific bacteria.Prokaryotic and eukaryotic cells answer key worksheets.Bacteria worksheets and answer key.
All prokaryotes have a single circular chromosome and lack a nucleus and membrane bound organelles.Displaying top 8 worksheets found for amoeba sisters prokaryotic vs eukaryotic answers.Prokaryotes and eukaryotes jflaherty1 kleinisd.
You have remained in right site to begin getting this info.Easy science for kids bacteria worksheet and quiz learn fun facts about animals the human body our planet and much more.Is an organism made of a single prokaryotic cell.
Some of the worksheets for this concept are amoeba sisters video recap amoeba sisters video recap prokaryotic eukaryotic cells prokaryotes bacteria work answers unit two the cell answers amoeba sisters pedigrees work answers ebook amoeba sisters pedigrees work answers amoeba sisters video recap.Terms in this set 23 what characteristics do all prokaryotes have in common.Acquire the prokaryotes bacteria worksheet answers colleague that we have enough money here and check out the link.
20 prokaryotes vs eukaryotes worksheet.Aug 13 2020 prokaryotes vs eukaryotes worksheet.Bacteria cells can only be unicellular pro before.
Singular circular chromosome and lack of a nucleus and membrane bound organelles.Prokaryotes bacteria worksheet answers worksheet answers prokaryotes bacteria worksheet answers recognizing the quirk ways to get this book prokaryotes bacteria worksheet answers is additionally useful.Prokaryotes no nucleus eukaryotes means organisms with a true nucleusdna cell membrane cytoplasmprokaryotic cells have no nucleus and no membrane bound organelles such as mitochondria er golgi etc.
Some of the worksheets for this concept are prokaryotic and eukaryotic cells organelles in eukaryotic cells prokaryotic and eukaryotic cells answer key answer key to organelles in eukaryotic cells parts of eukaryotic cell answer key eukaryotic cell structure answer key chapter 32.Amoeba sisters prokaryotic vs eukaryotic answers.Prokaryotes bacteria tbrightwell flashcards quizlet prokaryotes bacteria tbrightwell.
There are two major groups of prokaryotic organisms the kingdom.Bacteria worksheets and answer key teaching.Prokaryotes which includes bacteria are the simplest of all the cells.
These prokaryotic bacteria worksheets cover archaebacteria eubacteria bacteria shapes structures cluster type gram staining reproduction pasteurization sterilization and antibiotic resistance.Prokaryotic and eukaryotic cells bacteria cells 2.31 prokaryotes bacteria worksheet answers free worksheet.
Prokaryotic and eukaryotic cells answer key displaying top 8 worksheets found for this concept.Prokaryotes bacteria worksheet answers prokaryotes bacteria worksheet answers prokaryotes bacteria.Prokaryotes bacteria worksheet answers.